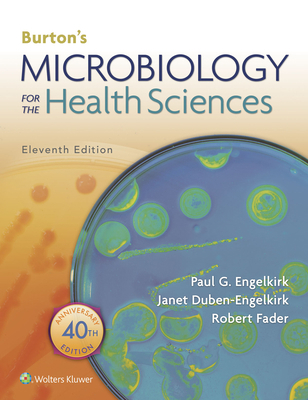

All Formats & Editions
1 - 5 of 5 results found
Burton's Microbiology for the Health Sciences
Edition Description
This fully updated Eleventh Edition of Burton's Microbiology for the Health Sciences remains the only microbiology text written specifically for the Allied Health/Nursing Introductory Microbiology course as outlined by the American Society for Microbiology. Emphasizing the relevance...
Edition Details
Format:Paperback
Language:English
ISBN:1496380460
Format: Paperback
Temporarily Unavailable
4 people are interested in this title.
We receive about 1 copy every 3-4 months.

Burton's Microbiology for the Health Sciences
Edition Details
Format:Paperback
Language:English
ISBN:1284242536
Format: Paperback
Temporarily Unavailable
1 person is interested in this title.
We receive fewer than 1 copy every 6 months.

BURTON'S MICROBIOLOGY FOR HEALTH SCIENCES 9E: .
Edition Description
This is a reference for health professionals and nursing students who need to learn the basic microbiological concepts involved in the care of patients and protection against infectious diseases.
Edition Details
Format:Paperback
Language:English
ISBN:1605476730
Format: Paperback
Condition:
$
6.39
Save $91.56!
List Price: $97.95
Almost Gone, Only 1 Left!

Burton's Microbiology for the Health Sciences
Edition Details
Format:Paperback
Language:English
ISBN:1451186347
Format: Paperback
Temporarily Unavailable
0 people are interested in this title.
We receive fewer than 1 copy every 6 months.

BURTON'S MICROBIOLOGY FOR THE HEALTH SCIENCES 8...
Edition Details
Format:Paperback
Language:English
ISBN:0781771951
Format: Paperback
Condition:
$
5.59
Save $71.36!
List Price: $76.95
Almost Gone, Only 1 Left!



